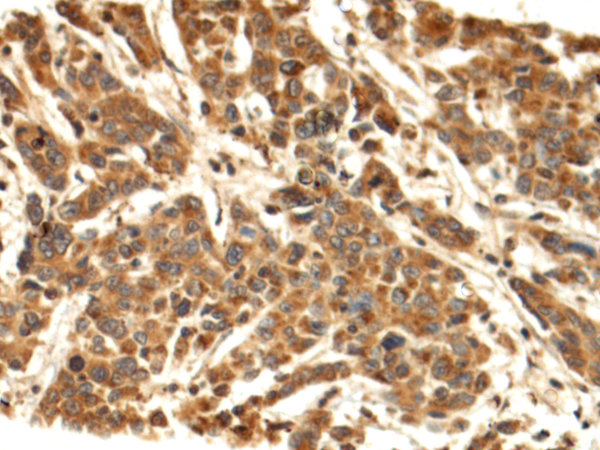

-
分类: 科研抗体货号: P00018别名: HSA; FDAHT; PRO0883; PRO0903; PRO1341应用: WB,IHC反应种属: Human, Mouse
-
分类: 科研抗体货号: 90010别名: LY-75; CLEC13B; DEC-205; GP200-MR6应用: FCM反应种属: Human
-
分类: 科研抗体货号: P00010别名:应用:反应种属: Biotin
-
分类: 科研抗体货号: P00015别名: ALS22; TUBA1; H2-ALPHA应用: WB,IHC反应种属: Human, Mouse, Rat
-
分类: 科研抗体货号: 90009别名: ALS10; TDP-43应用: WB,IHC,IF,FCM反应种属: Human
-
分类: 科研抗体货号: P00009别名: Lanoxin应用:反应种属: Digoxin
-
分类: 科研抗体货号: P00014别名: G3PD; GAPD; HEL-S-162eP应用: WB,IHC反应种属: Human, Mouse, Rat
-
分类: 科研抗体货号: 90008别名: OMR; ORM; ATPM; MOM2; ATP5A; hATP1; ATP5A1; MC5DN4; ATP5AL2; COXPD22; HEL-S-123m应用: FCM反应种属: Human
-
分类: 科研抗体货号: P00008别名:应用: WB反应种属: GFP transfected cells or Pure GFP protein
-
分类: 科研抗体货号: P00013别名: CDCBM; FEOM3; TUBB4; CDCBM1; CFEOM3; beta-4; CFEOM3A应用: WB,IHC反应种属: Human, Mouse, Rat

鄂公网安备42018502007531号
鄂公网安备42018502007531号

